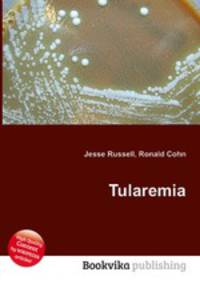
Tularemia

Поиск книг, учебников, пособий в онлайн-магазинах
Tularemia
Автор: Jesse Russell,Ronald Cohn, 109 стр., издатель: "Книга по Требованию", ISBN: 978-5-5085-6933-4High Quality Content by WIKIPEDIA articles! Tularemia (also known as Pahvant Valley plague,rabbit fever,deer fly fever, and Ohara's fever:286) is a serious infectious disease caused by the bacterium Francisella tularensis. A Gram-negative, nonmotile coccobacillus, the bacterium has several subspecies with varying degrees of virulence. The most important of those is F. tularensis tularensis (Type A), which is found in lagomorphs (rabbits and similar animals) in North America, and it is highly virulent in humans and domestic rabbits. F. tularensis palaearctica (Type B) occurs mainly in aquatic rodents (beavers, muskrats) in North America and in hares and small rodents in northern Eurasia. It is less virulent for humans and rabbits. The primary vectors are ticks and deer flies, but the disease can also be spread through other arthropods. The disease is named after Tulare County, California. Данное издание представляет собой компиляцию сведений, находящихся в свободном доступе в среде...
Рейтинг книги: 


 4 из 5, 3 голос(-ов).
4 из 5, 3 голос(-ов).



 4 из 5, 3 голос(-ов).
4 из 5, 3 голос(-ов).




